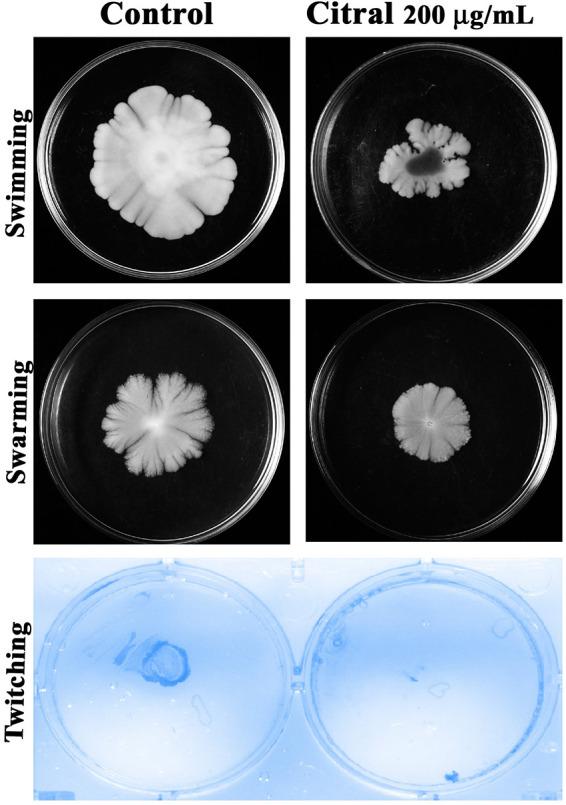
https://cdn.ncbi.nlm.nih.gov/pmc/blobs/0938/7677002/dba6054198c6/mSystems.00986-20-f0014.jpg

蛋白质组学和系统功能分析揭示了柠檬醛靶向鲍曼不动杆菌的抗生素耐药性、抗氧化防御以及与生物膜相关的双组分系统,以抑制生物膜和毒力特性。
Proteomic and Systematic Functional Profiling Unveils Citral Targeting Antibiotic Resistance, Antioxidant Defense, and Biofilm-Associated Two-Component Systems of Acinetobacter baumannii To Encumber Biofilm and Virulence Traits.
作者信息
Selvaraj Anthonymuthu, Valliammai Alaguvel, Muthuramalingam Pandiyan, Sethupathy Sivasamy, Subramenium Ganapathy Ashwinkumar, Ramesh Manikandan, Pandian Shunmugiah Karutha
机构信息
Department of Biotechnology, Alagappa University, Karaikudi, Tamil Nadu, India.
Department of Systems Biology, Science Research Centre, Yonsei University, Seoul, South Korea.
出版信息
mSystems. 2020 Nov 17;5(6):e00986-20. doi: 10.1128/mSystems.00986-20.
has been reported as a multidrug-resistant bacterium due to biofilms and antimicrobial resistance mechanisms. Hence, novel therapeutic strategies are necessary to overcome infections. This study revealed that citral at 200 μg/ml attenuated biofilms by up to 90% without affecting viability. Furthermore, microscopic analyses and assays confirmed the antibiofilm efficacy of citral. The global effect of citral on was evaluated by proteomic, transcriptional, and approaches. Two-dimensional (2D) gel electrophoresis and matrix-assisted laser desorption ionization-time of flight/time of flight (MALDI-TOF/TOF) analyses were used to assess the effect of citral on the cellular proteome. Quantitative real-time PCR (qPCR) analysis was done to validate the proteomic data and identify the differentially expressed genes. Protein-protein interactions, gene enrichment, and comparative gene network analyses were performed to explore the interactions and functional attributes of differentially expressed proteins of Global omics-based analyses revealed that citral targeted various mechanisms such as biofilm formation, antibiotic resistance, antioxidant defense, iron acquisition, and type II and type IV secretion systems. The results of antioxidant analyses and antibiotic sensitivity, blood survival, lipase, and hemolysis assays validated the proteomic results. Cytotoxicity analysis showed a nontoxic effect of citral on peripheral blood mononuclear cells (PBMCs). Overall, the current study unveiled that citral has multitarget efficacy to inhibit the biofilm formation and virulence of is a nosocomial-infection-causing bacterium and also possesses multidrug resistance to a wide range of conventional antibiotics. The biofilm-forming ability of plays a major role in its resistance and persistence. There is an alarming need for novel treatment strategies to control biofilm-associated issues. The present study demonstrated the strong antibiofilm and antivirulence efficacy of citral against In addition, proteomic analysis revealed the multitarget potential of citral against Furthermore, citral treatment enhances the susceptibility of to the host innate immune system and reactive oxygen species (ROS). Cytotoxicity analysis revealed the nonfatal effect of citral on human PBMCs. Therefore, citral could be the safest therapeutic compound and can be taken for further clinical evaluation for the treatment of biofilm-associated infections by .
由于生物膜和抗菌耐药机制,已被报道为一种多重耐药细菌。因此,需要新的治疗策略来克服感染。本研究表明,200μg/ml的柠檬醛可使生物膜减少多达90%,且不影响其活力。此外,显微镜分析和实验证实了柠檬醛的抗生物膜功效。通过蛋白质组学、转录组学和代谢组学方法评估了柠檬醛对该菌的整体影响。二维(2D)凝胶电泳和基质辅助激光解吸电离飞行时间/飞行时间(MALDI-TOF/TOF)分析用于评估柠檬醛对该菌细胞蛋白质组的影响。进行定量实时PCR(qPCR)分析以验证蛋白质组学数据并鉴定差异表达的基因。进行蛋白质-蛋白质相互作用、基因富集和比较基因网络分析以探索该菌差异表达蛋白质的相互作用和功能属性。基于全球组学的分析表明,柠檬醛靶向多种机制,如生物膜形成、抗生素耐药性、抗氧化防御、铁摄取以及II型和IV型分泌系统。抗氧化分析、抗生素敏感性、血液存活、脂肪酶和溶血实验的结果验证了蛋白质组学结果。细胞毒性分析表明柠檬醛对人外周血单核细胞(PBMC)无毒性作用。总体而言,当前研究揭示柠檬醛具有多靶点功效,可抑制该菌的生物膜形成和毒力。该菌是一种引起医院感染的细菌,并且对多种传统抗生素具有多重耐药性。该菌的生物膜形成能力在其耐药性和持续性中起主要作用。迫切需要新的治疗策略来控制与该菌生物膜相关的问题。本研究证明了柠檬醛对该菌具有强大的抗生物膜和抗毒力功效。此外,蛋白质组学分析揭示了柠檬醛对该菌的多靶点潜力。此外,柠檬醛处理增强了该菌对宿主先天免疫系统和活性氧(ROS)的敏感性。细胞毒性分析揭示了柠檬醛对人PBMC无致命作用。因此,柠檬醛可能是最安全的治疗化合物,可用于进一步的临床评估,以治疗该菌引起的生物膜相关感染。